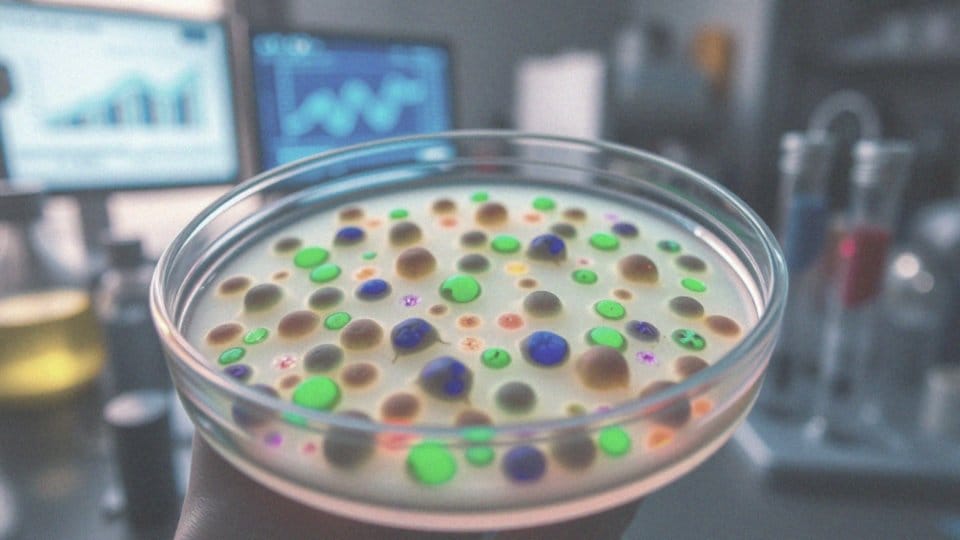

Spis treści
Czy marihuana leczy raka?
Marihuana często staje się tematem rozmów o jej właściwościach terapeutycznych, szczególnie w kontekście leczenia nowotworów. Liczne badania laboratoryjne oraz eksperymenty na zwierzętach sugerują, że kannabinoidy zawarte w tym narkotyku mogą spowalniać rozwój różnych typów nowotworów. Na przykład niektóre obserwacje wskazują, że te związki mają potencjał oddziaływać na komórki nowotworowe. Jednakże, obecny stan wiedzy naukowej nie dostarcza dowodów na skuteczność marihuany w terapii nowotworowej u ludzi.
Agencja Żywności i Leków (FDA) nie zaakceptowała marihuany jako leku na raka, co podkreśla potrzebę dalszych badań. Eksperci, tacy jak prof. Jacek Jassem, zaznaczają, że niezbędne są dodatkowe badania kliniczne, aby potwierdzić jakiekolwiek terapeutyczne działania marihuany w onkologii.
Chociaż marihuana nie leczy nowotworów, jest możliwe, że jej stosowanie przynosi ulgę w objawach choroby oraz w dolegliwościach związanych z tradycyjnym leczeniem, takich jak:
- ból,
- nudności,
- brak apetytu.
Terapie wspomagające, w których wykorzystuje się medyczną marihuanę, mogą być rozważane jako wsparcie dla pacjentów poddawanych standardowym metodom leczenia nowotworów. Ważne jednak, aby decyzję o jej użyciu podejmować po konsultacji z lekarzem, bazując na najnowszych badaniach klinicznych oraz zaleceniach specjalistów.
Jakie właściwości medyczne ma marihuana w kontekście nowotworów?
Marihuana, a zwłaszcza zawarte w niej kannabinoidy, posiada szereg właściwości medycznych, które mogą okazać się cenne w kontekście leczenia nowotworów. Jej działanie przeciwnowotworowe prowadzi do hamowania wzrostu komórek rakowych. Dzieje się tak dzięki stymulacji apoptozy, czyli procesowi śmierci komórek. Dodatkowo kannabinoidy mają wpływ na angiogenezę, co oznacza, że mogą ograniczyć powstawanie nowych naczyń krwionośnych, co wspiera leczenie guzów.
Medyczna marihuana jest często wykorzystywana w terapii wspomagającej dla chorych onkologicznie. Ulgę przynosi w:
- bólu nowotworowym,
- łagodzeniu skutków ubocznych chemioterapii, takich jak nudności czy wymioty,
- poprawie apetytu,
- poprawie samopoczucia pacjentów.
Właściwości przeciwzapalne kannabinoidów mogą również pomóc w redukcji napięcia mięśniowego oraz ogólnego dyskomfortu. Niemniej jednak, mimo obiecujących badań dotyczących potencjału fitokannabinoidów w terapii nowotworowej, konieczne są dalsze inwestygacje. Tylko poprzez kontynuację badań będziemy w stanie dogłębnie zrozumieć mechanizmy działania tych substancji oraz ocenić ich długoterminową skuteczność w leczeniu onkologicznych.
W jaki sposób marihuana wpływa na komórki nowotworowe?
Marihuana oddziałuje na komórki nowotworowe za pomocą kannabinoidów, które blokują specyficzne receptory wewnątrz tych komórek. Taki mechanizm może spowolnić rozwój nowotworów, co jest niezwykle istotne w kontekście terapii onkologicznych. Wyniki badań laboratoryjnych sugerują, że fitokannabinoidy mogą inicjować apoptozę, czyli proces zaprogramowanej śmierci komórek, co prowadzi do eliminacji uszkodzonych komórek nowotworowych.
Na przykład:
- delta-9-THC, jedna z najlepiej zbadanych substancji występujących w marihuanie, wykazuje zdolność do uszkadzania komórek nowotworowych,
- w kontekście raka wątroby kannabinoidy mają nie tylko działanie destrukcyjne, ale również hamują podział komórek oraz oddziałują na cykl komórkowy,
- marihuana ogranicza angiogenezę, co oznacza, że zapobiega powstawaniu nowych naczyń krwionośnych w pobliżu guzów.
W rezultacie, rozwój nowotworów może być spowolniony, co wspiera terapie onkologiczne. Chociaż marihuana wykazuje obiecujący potencjał w leczeniu nowotworów, niezbędne są dalsze badania, aby dokładniej potwierdzić jej skuteczność i bezpieczeństwo dla pacjentów.
Jak kannabinoidy hamują wzrost nowotworów?
Kannabinoidy wpływają na wzrost nowotworów na kilka sposobów:
- indukują apoptozę komórek nowotworowych, co prowadzi do ich programowanej śmierci,
- zatrzymują cykl komórkowy w fazie G1, co skutkuje zahamowaniem proliferacji komórek nowotworowych,
- inhibicja angiogenezy, czyli ograniczenie tworzenia nowych naczyń krwionośnych, które zaopatrują guzy, znacznie spowalnia ich rozwój.
Na przykład, w eksperymentach z wykorzystaniem komórek zwierzęcych oraz w hodowlach komórkowych zaobserwowano, że olej konopny CBD (kannabidiol) wykazuje korzystny wpływ na komórki nowotworowe, co podkreśla jego terapeutyczny potencjał w kontekście onkologii. Warto także zauważyć, że działanie przeciwnowotworowe kannabinoidów nie tylko ogranicza rozwój nowotworów, ale również może przyczynić się do zmniejszenia ryzyka przerzutów, co jest niezwykle istotne w procederze leczenia nowotworów, w tym także guzów mózgu.
Jak marihuana działa na receptory kannabinoidowe w kontekście nowotworów?
Marihuana oddziałuje na receptory kannabinoidowe CB1 i CB2, które odgrywają kluczową rolę w interakcji z komórkami nowotworowymi. Aktywacja tych receptorów prowadzi do różnorodnych efektów terapeutycznych, w tym:
- hamowania wzrostu nowotworów,
- indukcji apoptozy, co jest procesem prowadzącym do śmierci komórek rakowych,
- ograniczania proliferacji komórek nowotworowych.
Kannabinoidy mają zdolność ograniczania proliferacji komórek nowotworowych, co podkreśla ich obiecujący potencjał w dziedzinie onkologii. Warto również zwrócić uwagę, że marihuana wspiera układ odpornościowy, co jest niezwykle ważne w walce z rakiem. Badania pokazują, że aktywacja receptorów kannabinoidowych zmienia funkcję komórek odpornościowych, zwiększając ich zdolność do identyfikowania i eliminowania komórek nowotworowych.
Na przykład delta-9-THC, główny kannabinoid występujący w marihuanie, hamuje angiogenezę. Oznacza to, że może ograniczać rozwój nowych naczyń krwionośnych w guzach, co jest kluczowe dla ich wzrostu oraz rozprzestrzeniania się. Olej konopny CBD również oddziałuje na te receptory, co sugeruje jego terapeutyczne możliwości w kontekście nowotworów. Fitokannabinoidy stymulują proces usuwania uszkodzonych komórek, co jest niezwykle istotne podczas terapii nowotworowej. Te wszystkie mechanizmy sprawiają, że marihuana staje się interesującym obiektem badań nad nowoczesnymi metodami leczenia onkologicznego.
Jak marihuana i CBD wpływają na objawy nowotworowe?

Marihuana oraz CBD oddziałują na objawy nowotworowe na różne sposoby. Medyczna marihuana jest często stosowana w celu złagodzenia bólu, co ma ogromne znaczenie dla pacjentów cierpiących z powodu przewlekłego dyskomfortu. Poza tym, kannabinoidy zawarte w marihuanie przynoszą ulgę w nudnościach i wymiotach, które nierzadko pojawiają się po chemioterapii. Wielu pacjentów dostrzega również poprawę apetytu oraz nastroju, co jest niezwykle istotne w trakcie zmagania się z poważną chorobą.
Z kolei CBD, dzięki swoim właściwościom przeciwzapalnym, pomaga w łagodzeniu napięcia mięśniowego oraz ogólnego dyskomfortu, co może przyczynić się do lepszej jakości życia. Badania wskazują, że CBD może wspierać chemioterapię, pozytywnie wpływając na samopoczucie oraz wyniki leczenia.
Działanie marihuany i CBD w kontekście objawów nowotworowych prowadzi do odczucia ulgi oraz poprawy komfortu psychicznego, co jest kluczowe dla pacjentów, którzy stawiają czoła trudnościom związanym z chorobą. Należy pamiętać, że marihuana nie likwiduje samego nowotworu, ale jej zastosowanie jako elementu terapii wspomagającej może przynieść korzyści w łagodzeniu objawów i poprawie jakości życia na każdym etapie choroby.
Każde podanie marihuany i CBD powinno być ściśle monitorowane przez lekarza, co zapewnia bezpieczeństwo i umożliwia odpowiednie dobranie dawki substancji do indywidualnych potrzeb pacjenta.
Jakie są efekty terapeutyczne stosowania CBD w onkologii?
CBD, znany jako kannabidiol, ma znaczące znaczenie w terapii nowotworowej ze względu na swoje właściwości zdrowotne. Przede wszystkim potrafi:
- spowolnić rozwój komórek rakowych,
- wywołać apoptozę, co prowadzi do ich naturalnej eliminacji,
- ograniczać wzrost guzów, w tym glejaków oraz nowotworów piersi,
- zwiększyć efektywność terapii radiowej u chorych na raka płuc,
- łagodzić nieprzyjemne skutki uboczne chemioterapii, takie jak nudności czy wymioty.
Co więcej, kannabidiol łagodzi również napięcie mięśniowe, co jest niezwykle ważne w onkologii. CBD oddziałuje na ekspresję genu Id-1, co może ograniczać rozprzestrzenianie się nowotworów. Systematyczne stosowanie kannabidiolu polepsza zarówno stan psychiczny, jak i fizyczny pacjentów, co jest kluczowe w czasie terapii nowotworowej. Terapeutyczne efekty działania CBD w onkologii podkreślają jego obiecujący potencjał w połączeniu z tradycyjnymi metodami leczenia, dając pacjentom ulgę oraz nadzieję na lepszą jakość życia.
Czy marihuana może wspierać terapię onkologiczną?
Medyczna marihuana ma potencjał, by wspierać terapię onkologiczną, łagodząc różne objawy nowotworowe oraz skutki uboczne leczenia. Jej zastosowanie w chemioterapii oraz radioterapii może przynieść ulgę w:
- bólu,
- nudnościach,
- wymiotach,
- braku apetytu.
To jest szczególnie istotne dla pacjentów borykających się z tymi dolegliwościami. Badania wskazują, iż kannabinoidy, będące kluczowymi składnikami marihuany, mogą pozytywnie wpłynąć na nastrój oraz zredukować stres związany z intensywnym leczeniem. W niektórych sytuacjach marihuana pełni rolę medycyny wspomagającej, ułatwiając organizmowi adaptację po terapiach onkologicznych. Co więcej, istnieją przesłanki, które sugerują, że marihuana może okazać się pomocna już we wczesnych stadiach leczenia, na przykład w przypadku raka piersi. To zastosowanie potwierdza rosnące zainteresowanie terapeutycznymi właściwościami marihuany w onkologii, zarówno ze strony pacjentów, jak i specjalistów.
Należy jednak pamiętać, że stosowanie marihuany powinno odbywać się zawsze pod ścisłą kontrolą lekarza. Bezpieczeństwo pacjentów oraz możliwość wystąpienia interakcji z innymi lekami to aspekty, które wymagają szczególnej uwagi. Dlatego kluczowe jest, aby pacjenci współpracowali z lekarzami w celu ustalenia optymalnej formy i dawki marihuany, dopasowanej do ich specyficznych potrzeb zdrowotnych.
Jakie są korzyści z leczenia medyczną marihuaną podczas chemioterapii?
Medyczna marihuana oferuje szereg zalet pacjentom poddawanym chemioterapii. Przede wszystkim pomaga w:
- łagodzeniu bólów nowotworowych,
- łagodzeniu skutków ubocznych związanych z leczeniem, takich jak nudności i wymioty,
- poprawie samopoczucia pacjentów dzięki właściwościom przeciwwymiotnym oraz stymulującym apetyt,
- działaniu przeciwlękowemu, co korzystnie wpływa na psychikę osób borykających się z poważnymi problemami zdrowotnymi,
- przyspieszaniu procesu rehabilitacji po chemioterapii.
W rezultacie, medyczna marihuana pomaga nie tylko w łagodzeniu dolegliwości fizycznych, ale również podnosi jakość życia pacjentów. Istotne jest jednak, aby jej użycie było starannie monitorowane przez specjalistów. Takie podejście minimalizuje ryzyko interakcji z innymi lekami i pozwala na dostosowanie dawkowania do specyficznych potrzeb każdej osoby.
Jakie są działania uboczne stosowania marihuany w leczeniu nowotworów?

Wykorzystanie marihuany w terapii nowotworowej wiąże się z różnymi potencjalnymi skutkami ubocznymi, które powinny być starannie rozważone przed podjęciem decyzji o jej zastosowaniu. Wyniki badań epidemiologicznych wskazują na możliwy związek między jej używaniem a podniesionym ryzykiem pojawienia się nowotworów, co podkreśla konieczność zachowania ostrożności.
Do najczęściej zgłaszanych efektów ubocznych należą:
- trudności z pamięcią,
- problemy z myśleniem,
- ograniczenia w zakresie koordynacji ruchowej,
- uczucie lęku,
- depresja.
Interakcje marihuany z innymi substancjami, w tym z lekami stosowanymi w terapii nowotworowej, są również niezwykle istotne, ponieważ mogą wpływać na skuteczność leczenia. Dlatego niezbędne jest przeprowadzanie regularnych konsultacji medycznych, które pozwolą na monitorowanie ewentualnych skutków ubocznych. Warto również wziąć pod uwagę, że marihuana może zmieniać sposób, w jaki organizm reaguje na terapie onkologiczne, co czasami może prowadzić do konieczności dostosowania dawek leków. Wszystkie decyzje dotyczące stosowania marihuany powinny opierać się na rzetelnych informacjach oraz zindywidualizowanych potrzebach zdrowotnych pacjenta, co przyczynia się do bezpieczniejszego podejścia do leczenia.
Jakie są wyniki badań klinicznych dotyczących stosowania marihuany w walce z rakiem?
Wyniki badań klinicznych dotyczących wykorzystania marihuany w walce z rakiem pozostają wciąż niejednoznaczne. Laboratoria odkrywają, że kannabinoidy mogą hamować wzrost komórek nowotworowych, lecz wiele z tych obserwacji nie uzyskało potwierdzenia w badaniach przeprowadzonych na ludziach.
Generalnie można stwierdzić, że terapeutyczne właściwości marihuany w kontekście leczenia nowotworów są ograniczone. Przed rokiem 2017 badania nad medyczną marihuaną w onkologii były raczej sporadyczne, ale od tego czasu tematyka ta zyskała na znaczeniu, co zaowocowało wieloma nowymi projektami badawczymi.
Obecnie badacze skupiają się na potencjale CBD i THC jako wsparcia w tradycyjnych metodach leczenia, takich jak chemioterapia. Pojawiające się wyniki sugerują, że marihuana może przyczynić się do poprawy jakości życia pacjentów, łagodząc objawy takie jak:
- ból,
- nudności.
Jednak ciągle brakuje solidnych dowodów naukowych, które pozwoliłyby na zalecenie jej jako jedynego środka w terapii nowotworowej. W związku z tym zdecydowanie potrzebne są dalsze badania kliniczne, aby lepiej zrozumieć zarówno korzyści, jak i ewentualne ryzyko związane z jej zastosowaniem w onkologii. Choć marihuana nie leczy nowotworów, jej rola jako wsparcie w terapii może okazać się obiecująca. Wszelkie decyzje dotyczące jej stosowania powinny być starannie konsultowane z lekarzem.
Jak wygląda aktualna sytuacja prawna dotycząca marihuany w onkologii?
Sytuacja prawna dotycząca marihuany w kontekście onkologii jest zróżnicowana w różnych krajach i regionach. W wielu miejscach medyczna marihuana została zalegalizowana, co umożliwia jej przepisywanie pacjentom cierpiącym na nowotwory. Dzięki temu mogą oni łagodzić nieprzyjemne objawy, takie jak:
- ból,
- nudności,
- brak apetytu,
- które często towarzyszą leczeniu.
Niestety, w innych krajach użycie marihuany w celach medycznych jest wciąż zabronione, co skutkuje ograniczonym dostępem do jej potencjalnych korzyści zdrowotnych. W Stanach Zjednoczonych sytuacja jest skomplikowana – mimo że wiele stanów zaczyna legalizować medyczną marihuanę, Agencja ds. Żywności i Leków (FDA) nie uznała jej za oficjalny lek. To z kolei powoduje problemy z uzyskaniem formalnych wytycznych dotyczących jej zastosowania w terapii onkologicznej.
W rezultacie, pacjenci często muszą sami gromadzić informacje o lokalnych przepisach i konsultować się ze swoimi lekarzami. Globalnie rzecz biorąc, podejście do prawnych aspektów marihuany różni się znacznie. Na przykład w Kanadzie oraz Urugwaju pacjenci mają łatwy dostęp do niej, co sprzyja badaniom nad jej właściwościami terapeutycznymi. Europa prezentuje całą gamę podejść – to, jakie regulacje obowiązują, zależy od decyzji poszczególnych państw członkowskich.
W świetle dynamicznych zmian w przepisach, istotne jest, aby pacjenci pozostawali dobrze poinformowani. Śledzenie aktualnych regulacji dotyczących marihuany w onkologii pozwala na podejmowanie świadomych decyzji. Konsultacje z lekarzem oraz odpowiednia dokumentacja medyczna odgrywają kluczową rolę w procesie leczenia, umożliwiając dostosowanie terapii do indywidualnych potrzeb każdego pacjenta.





